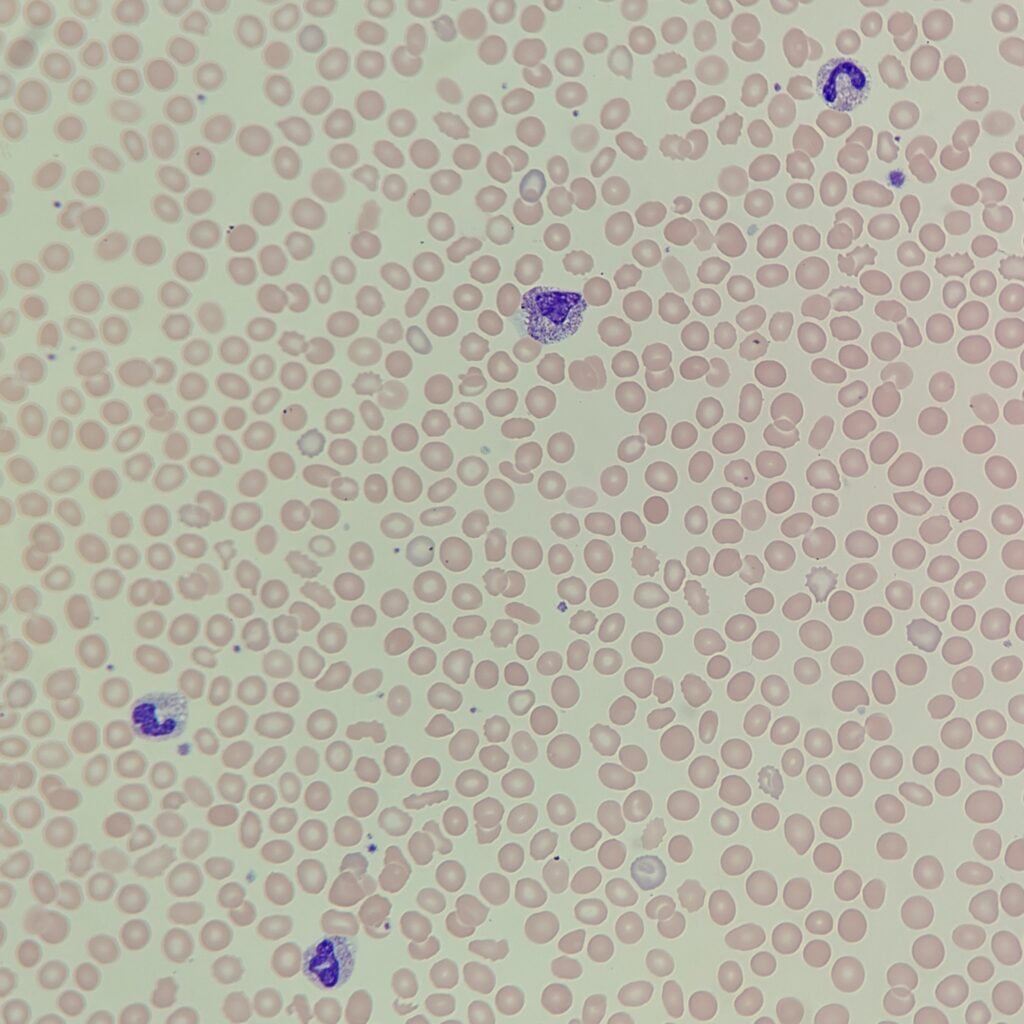
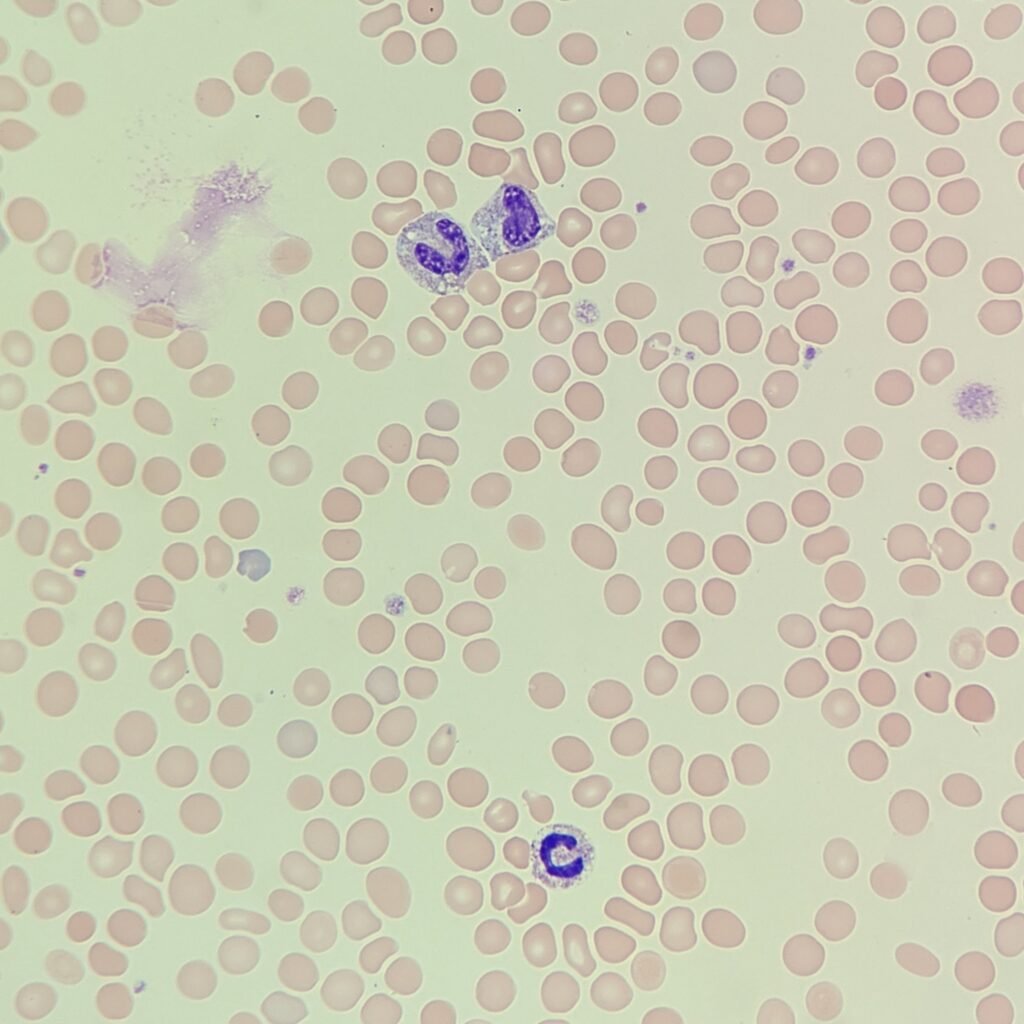
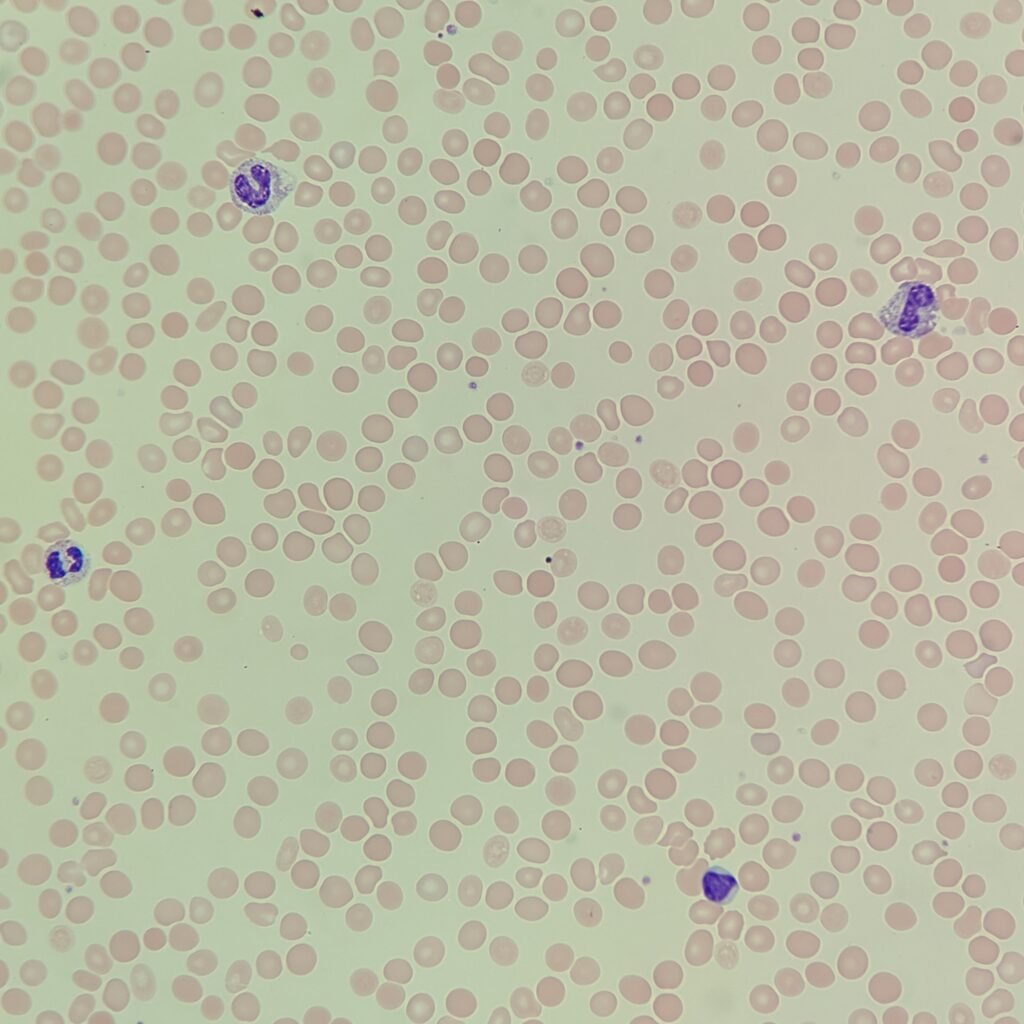
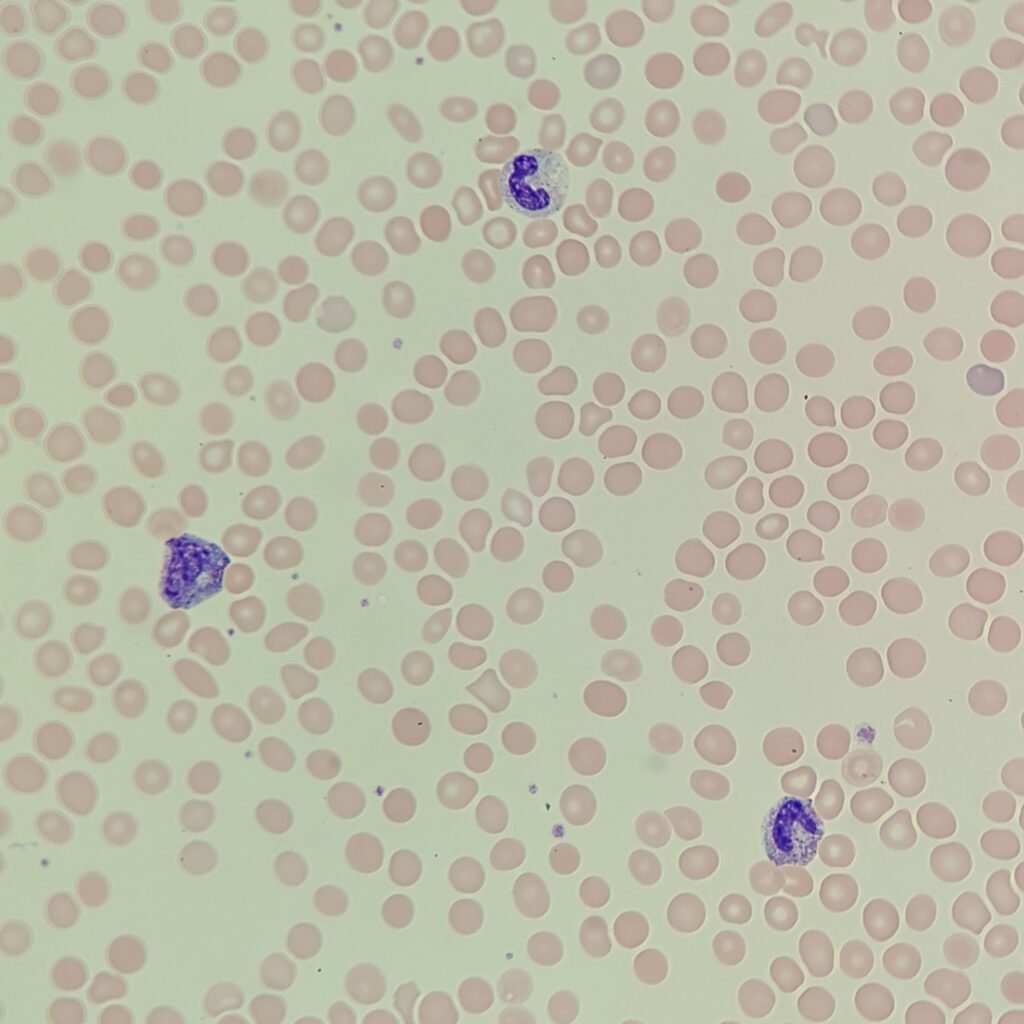
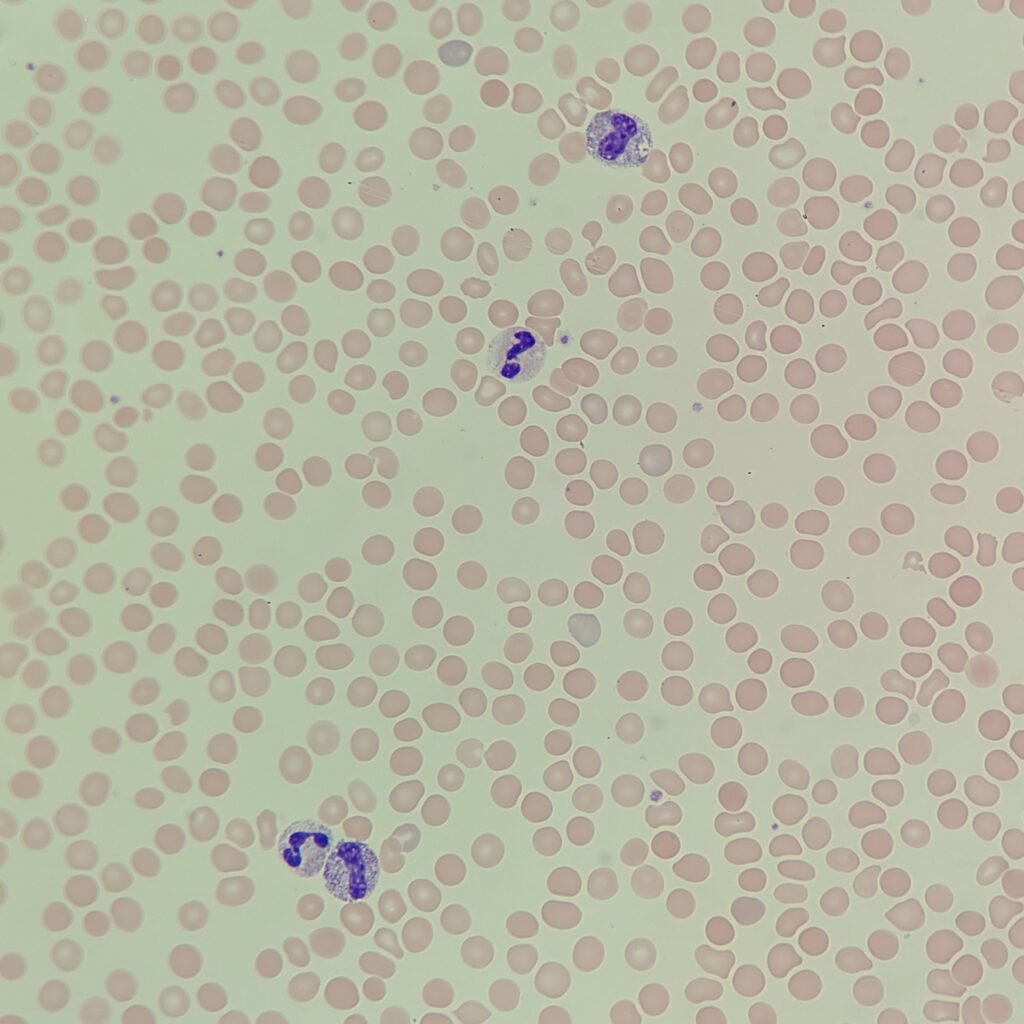
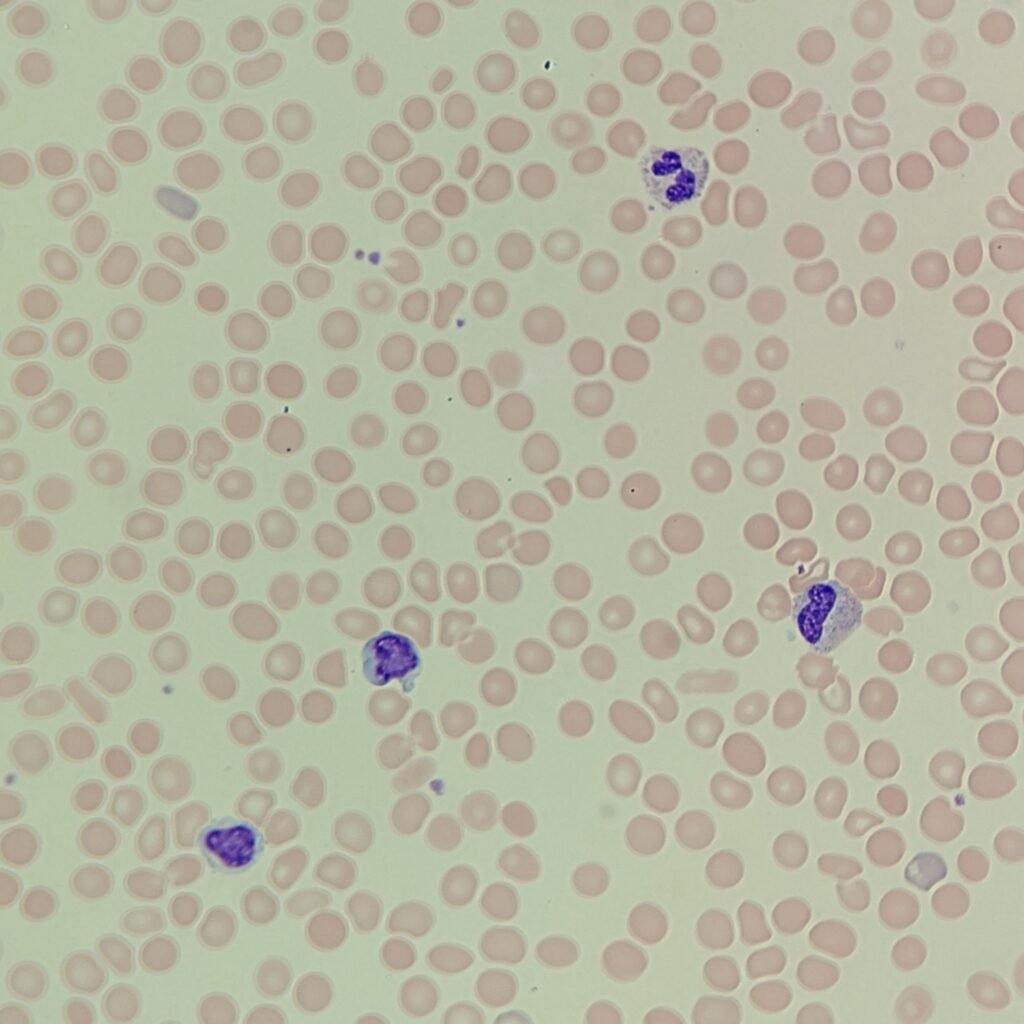
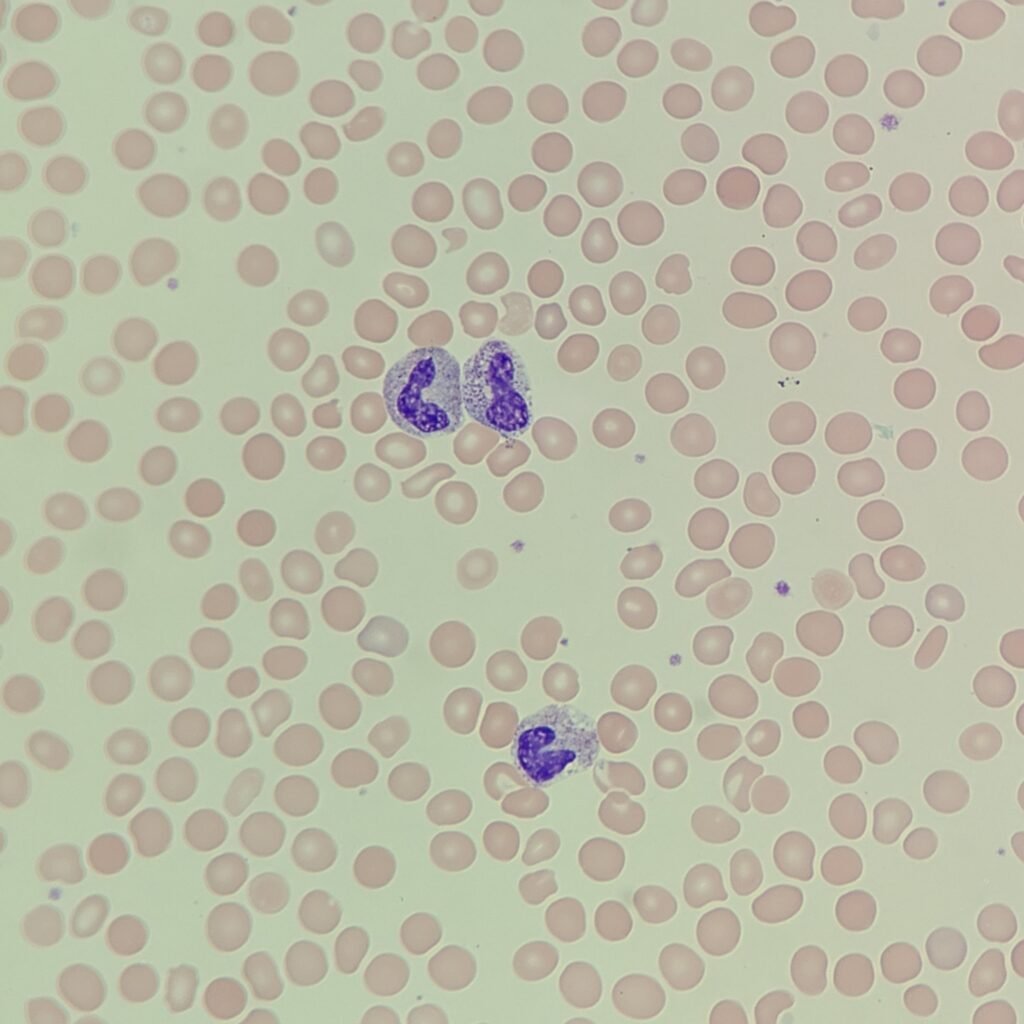
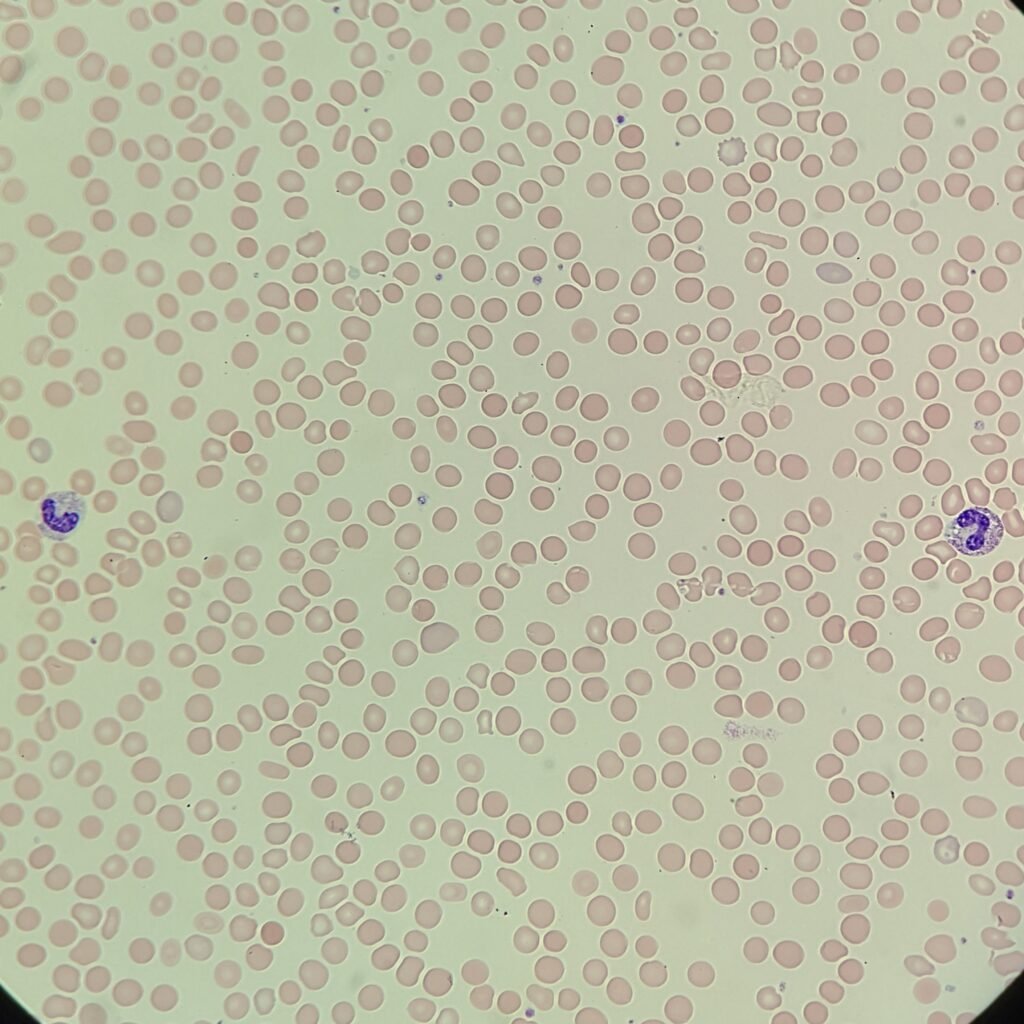
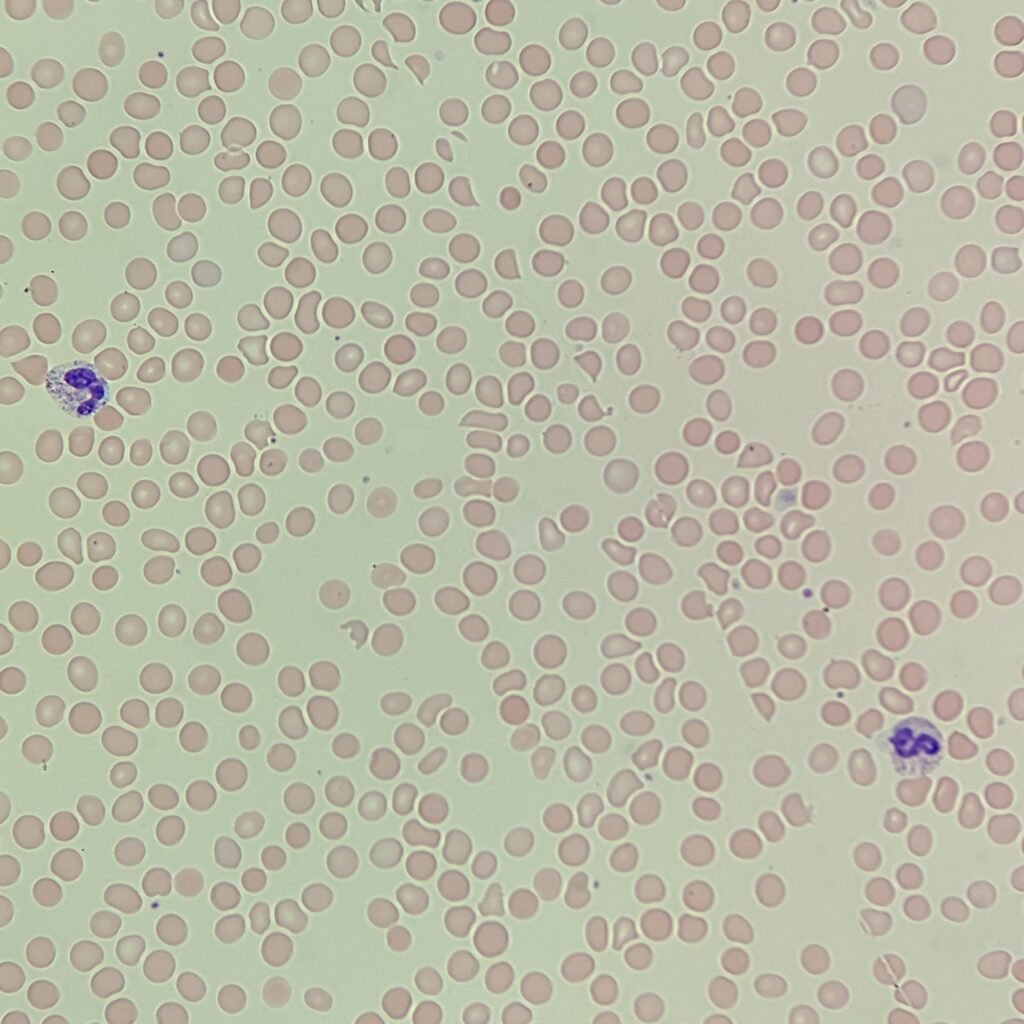
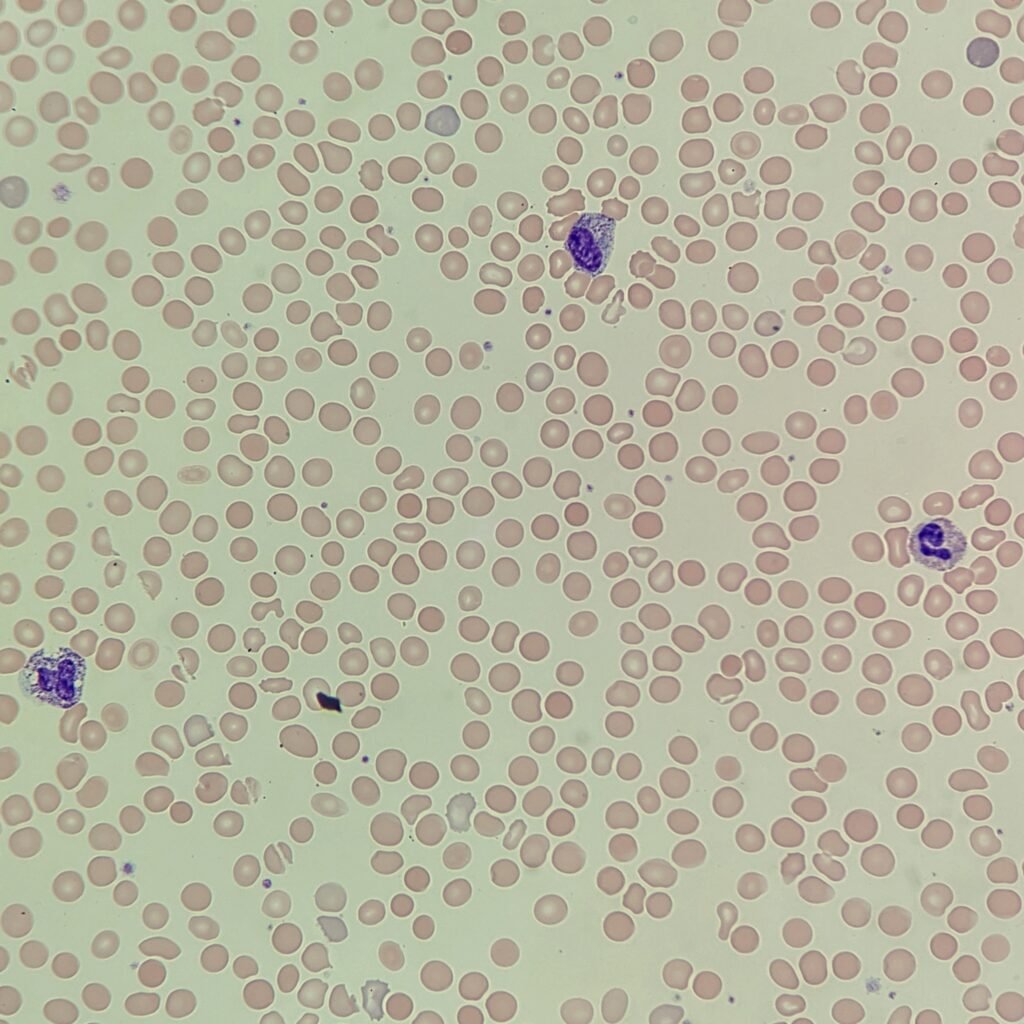
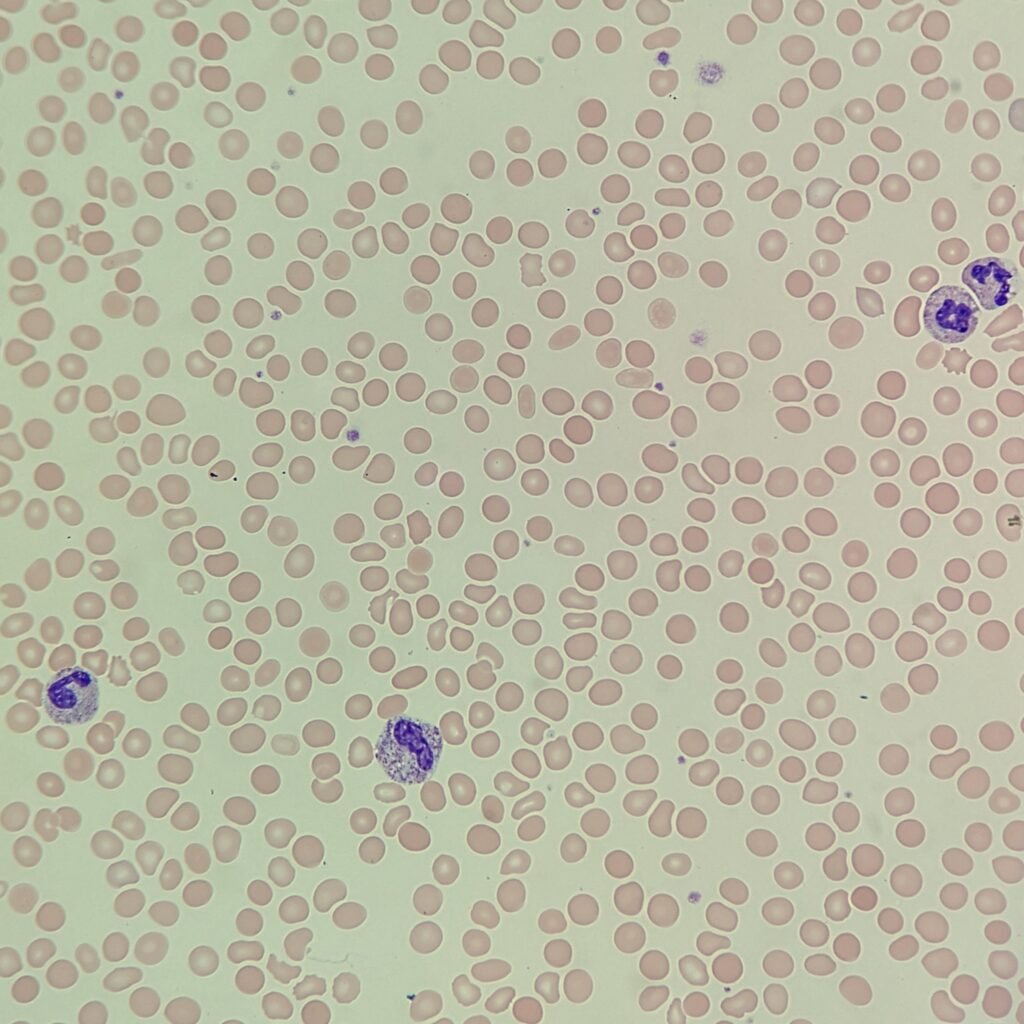
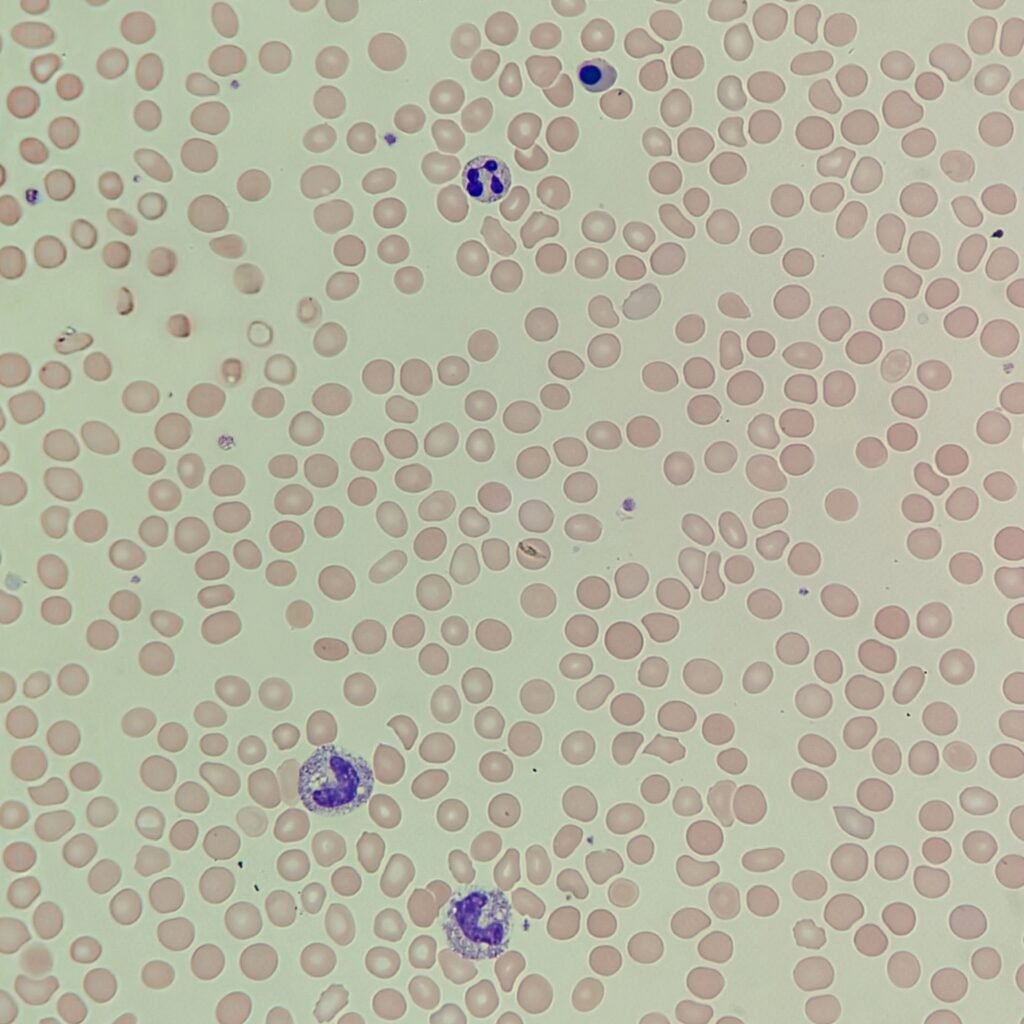
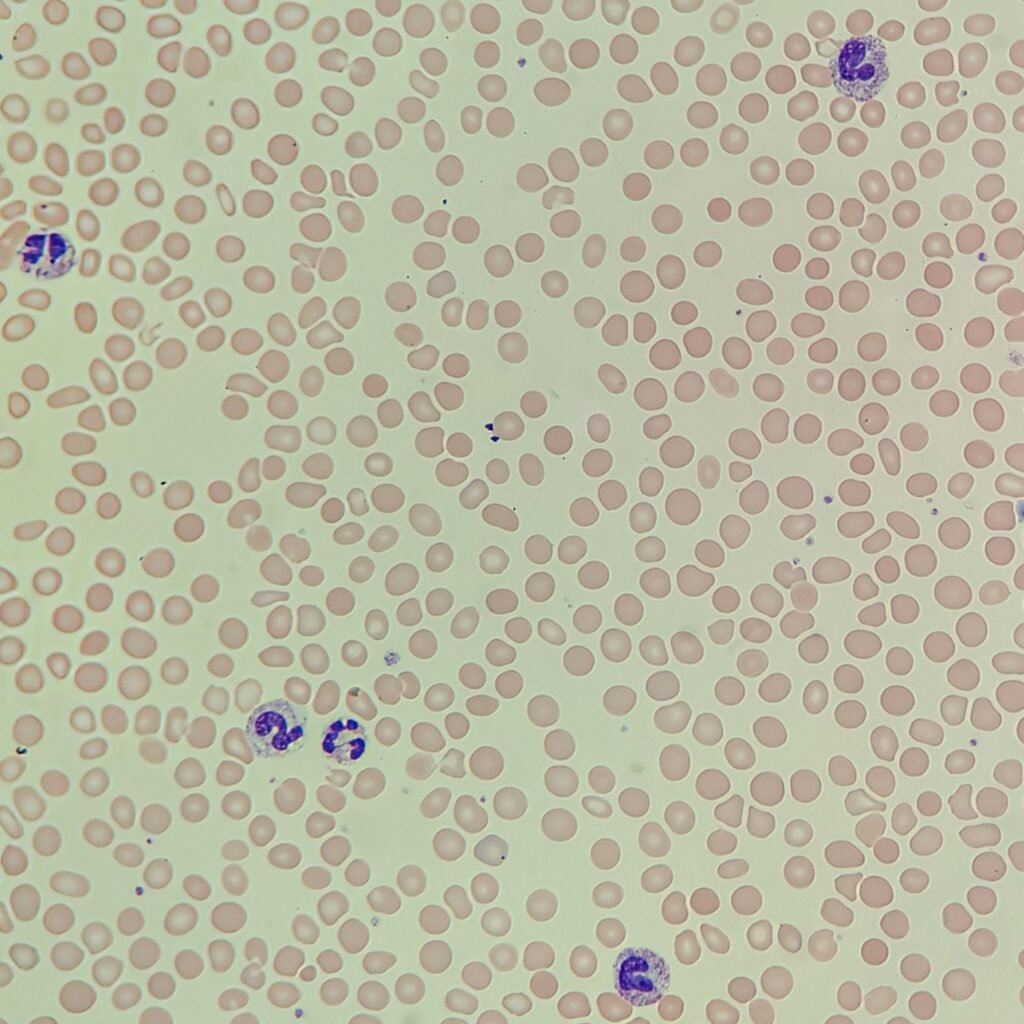
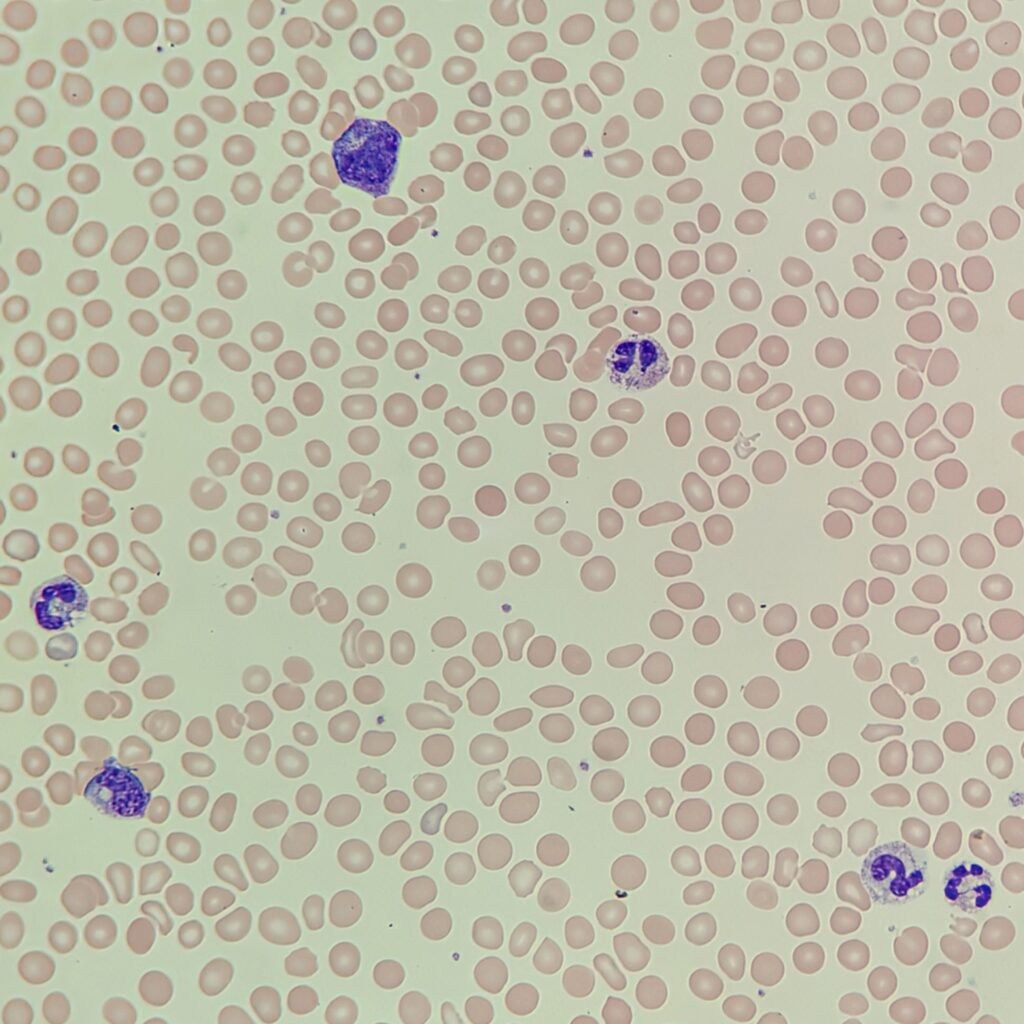
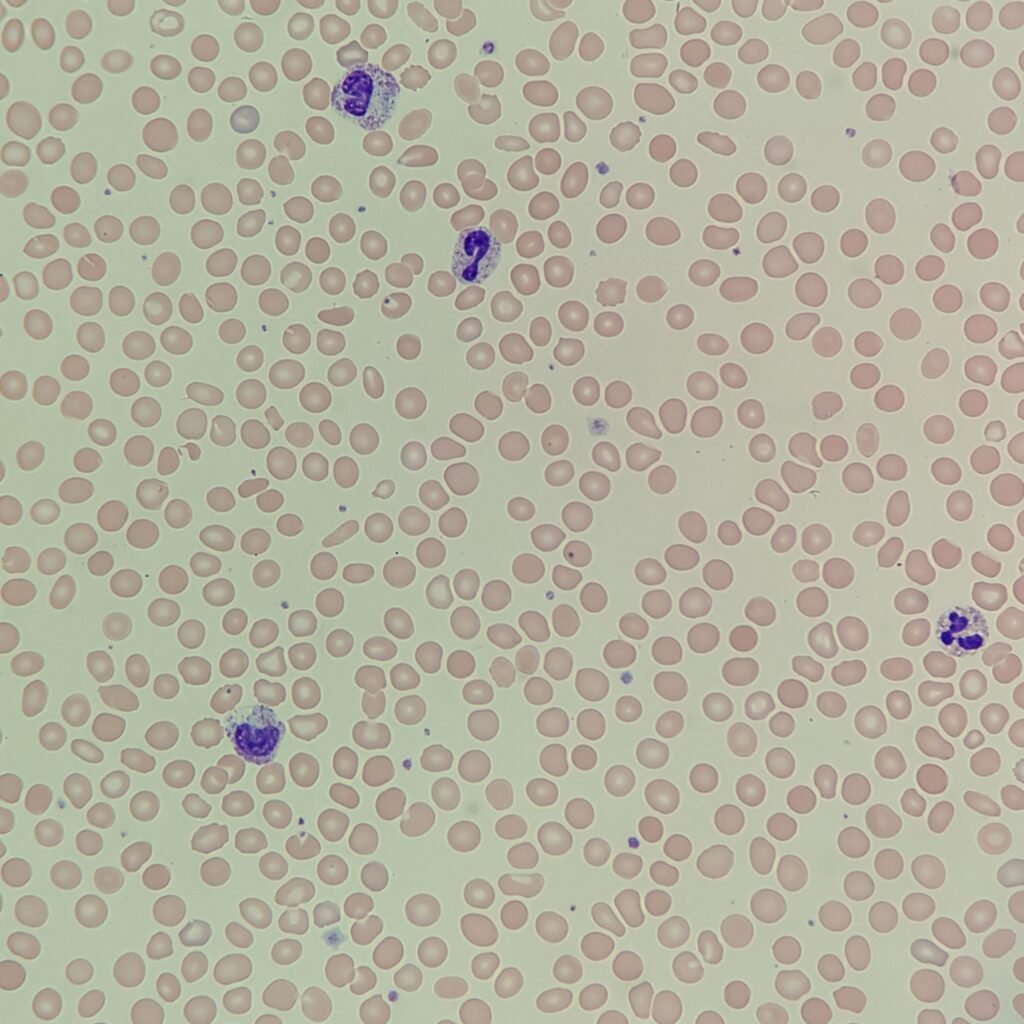
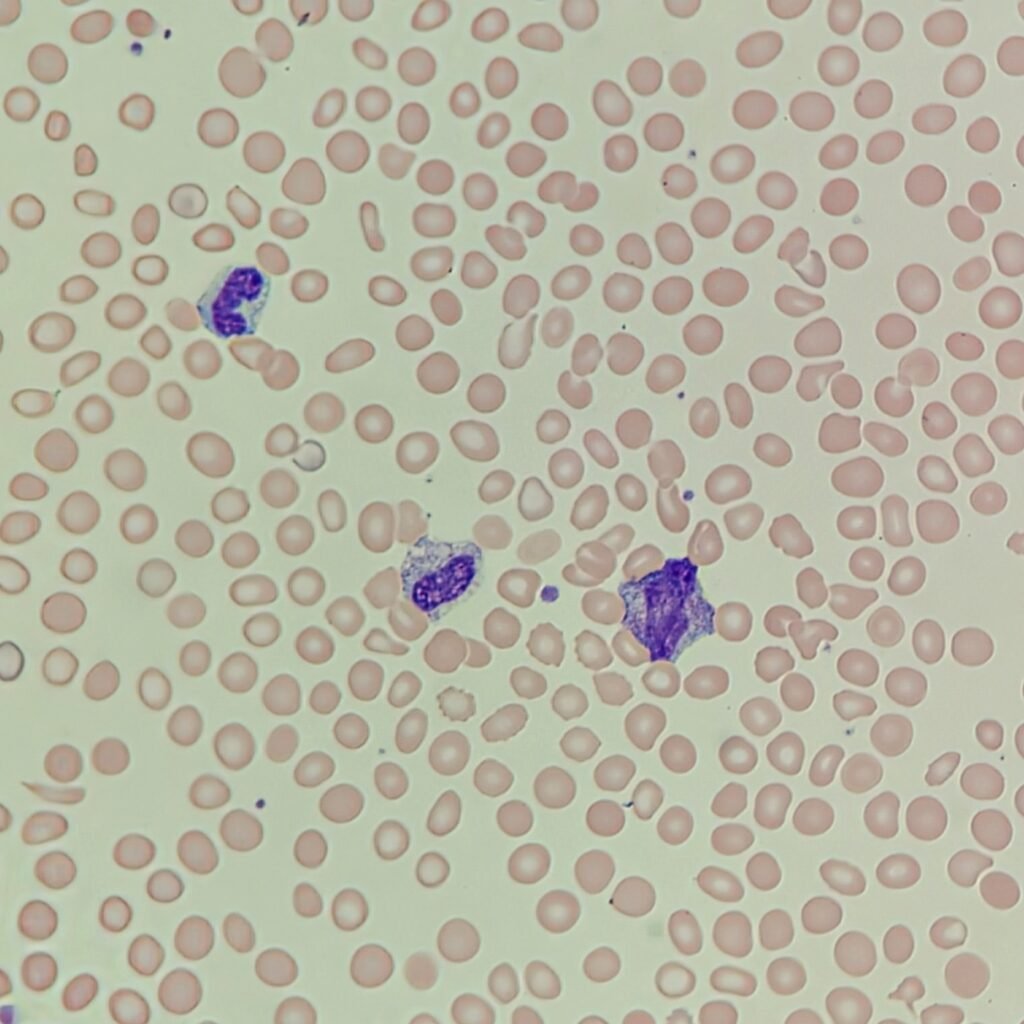
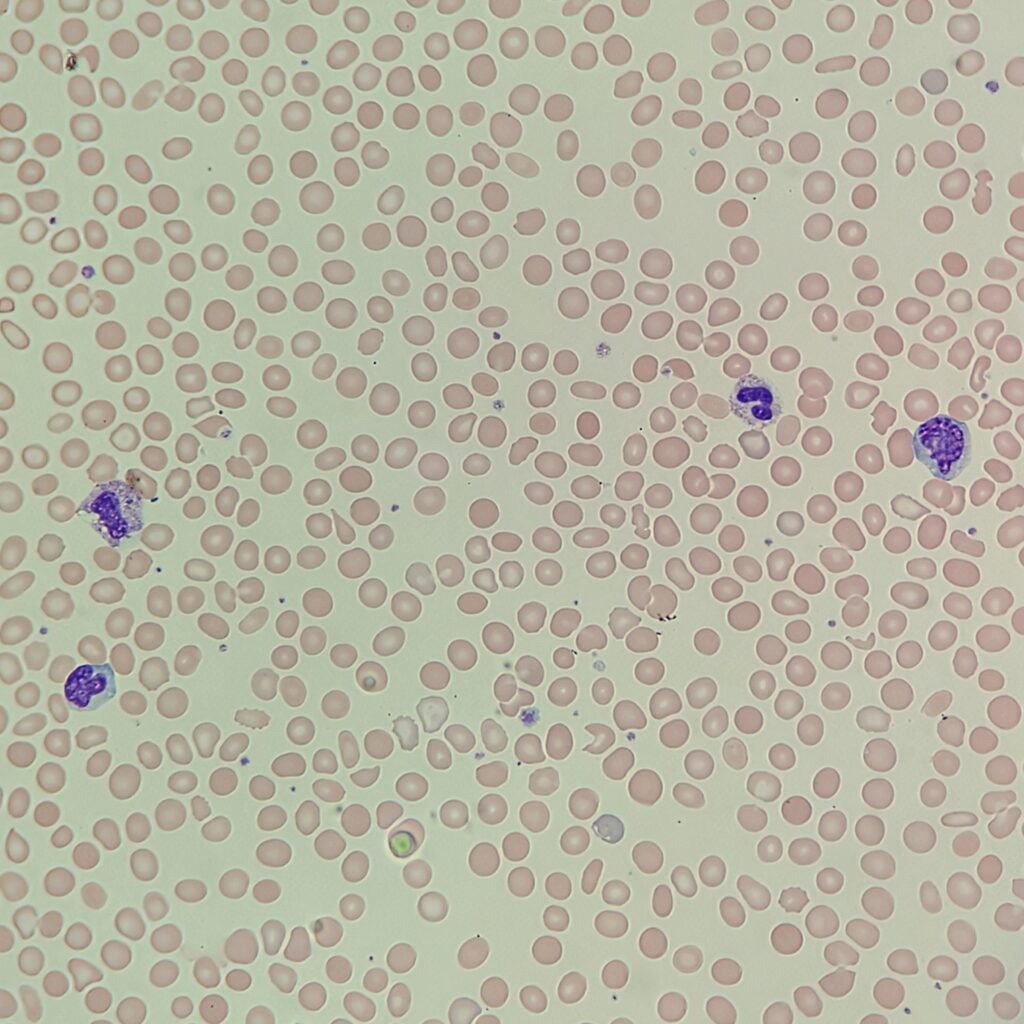
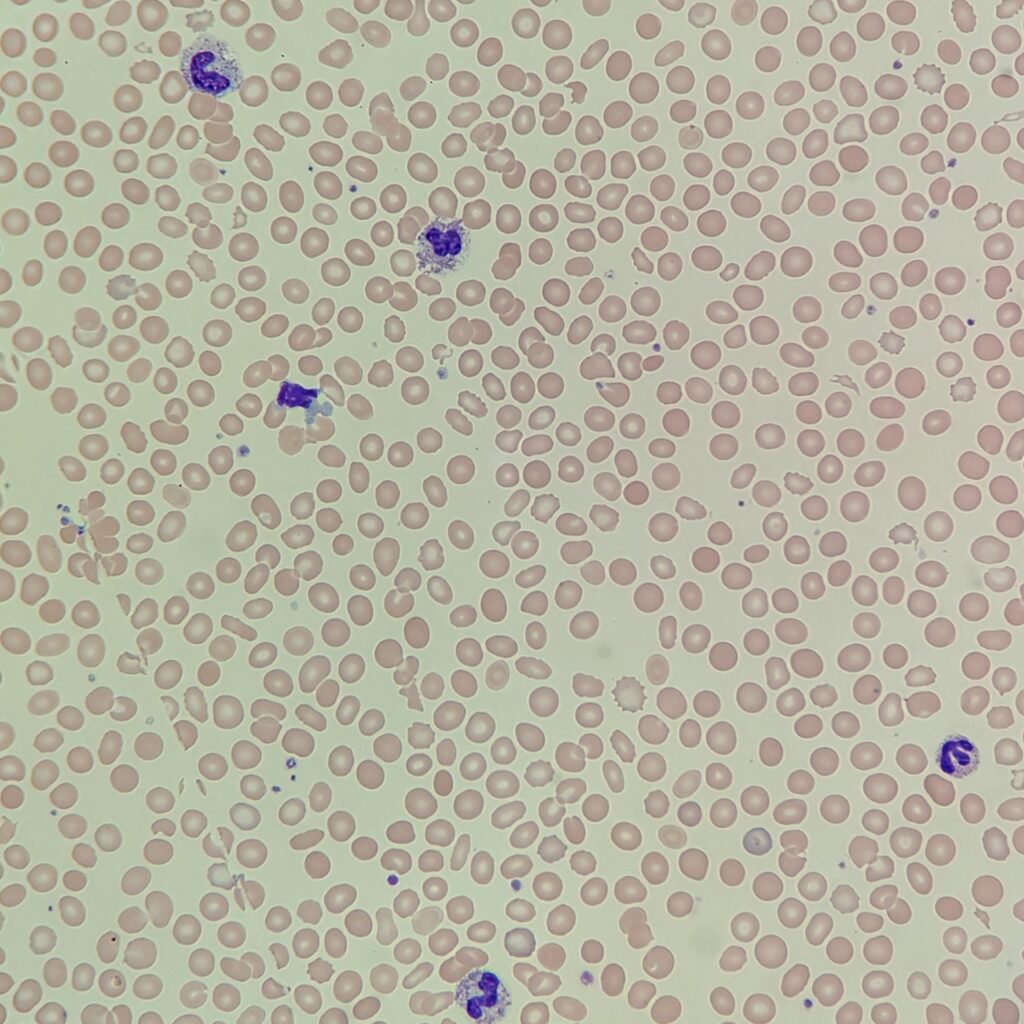
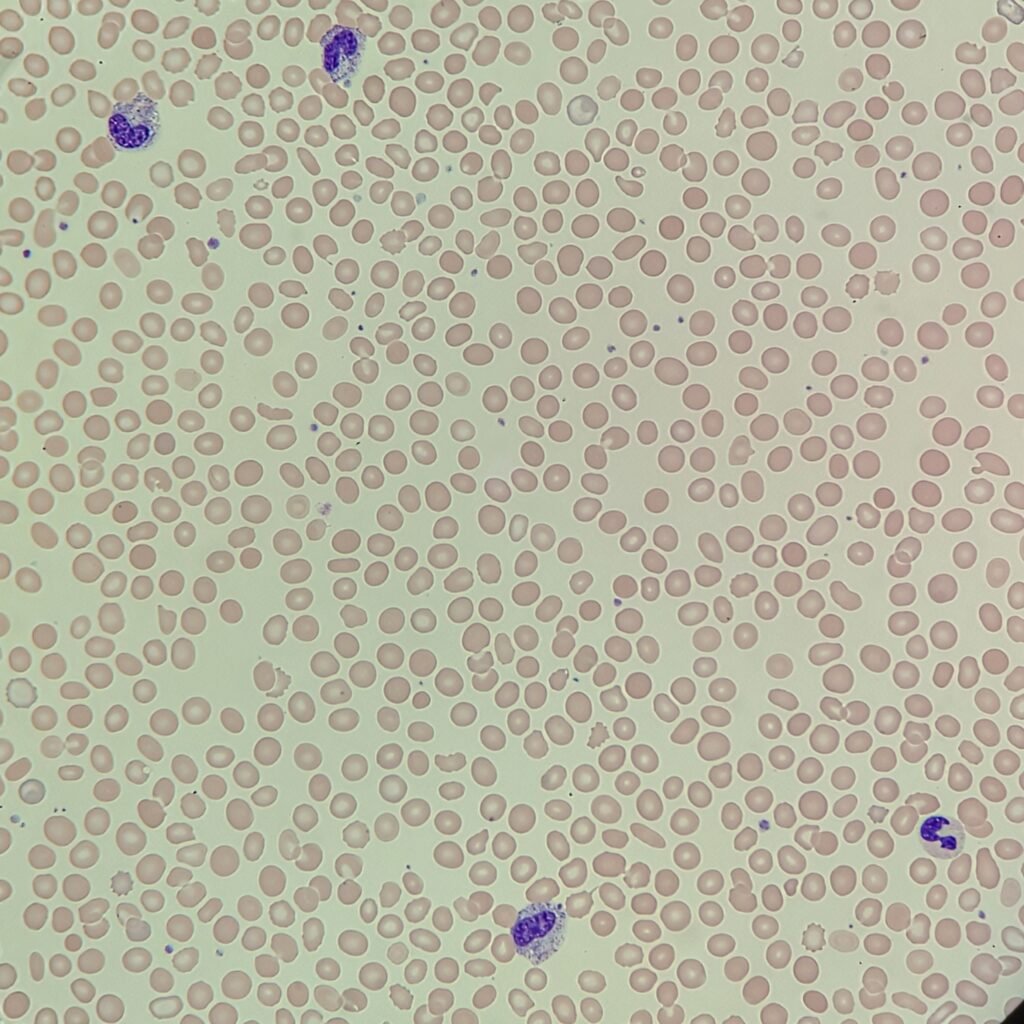
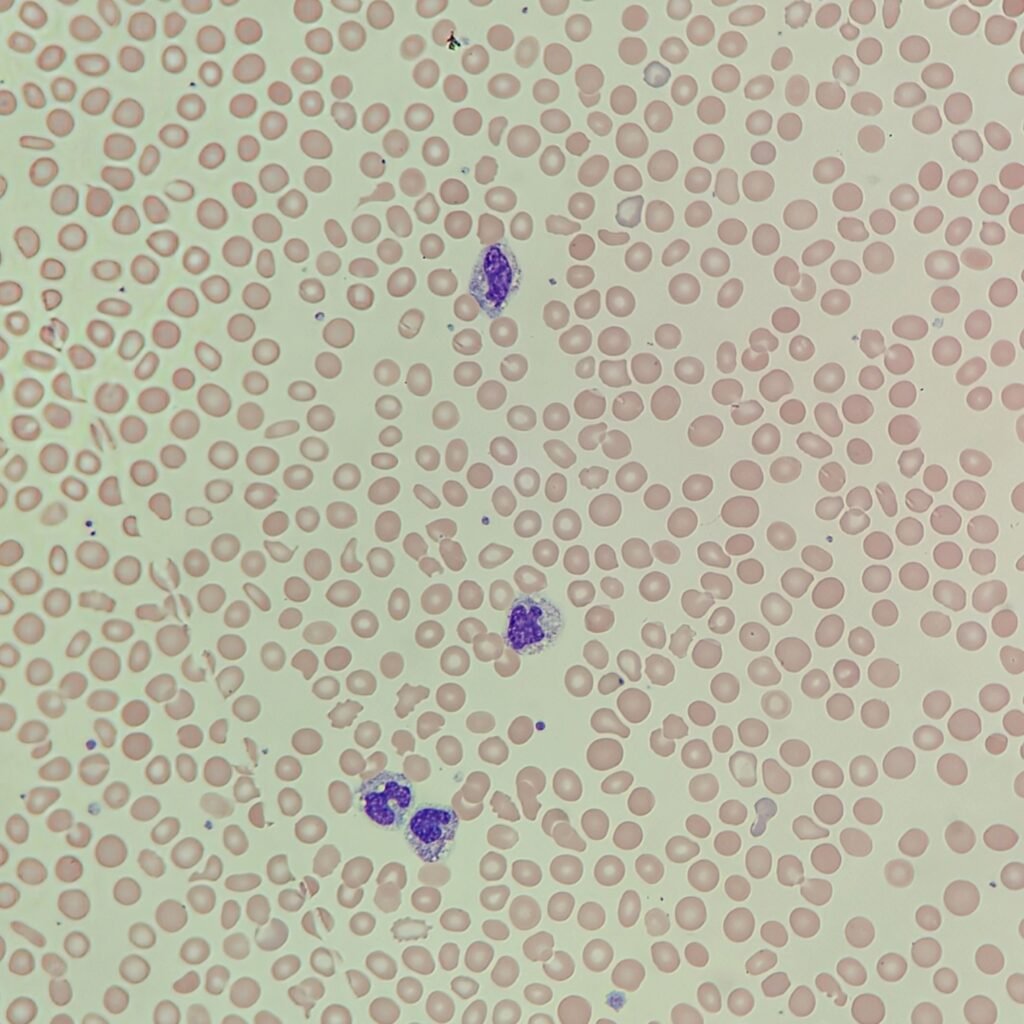
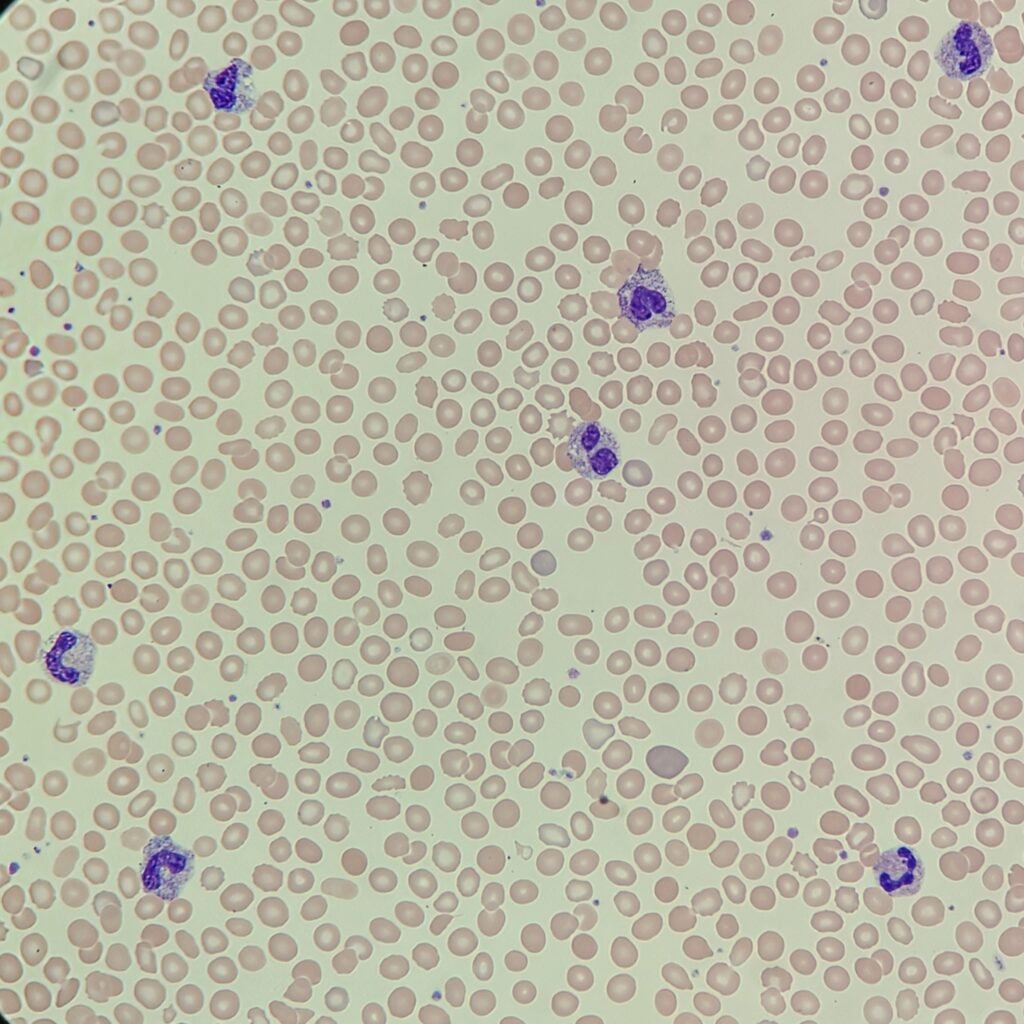
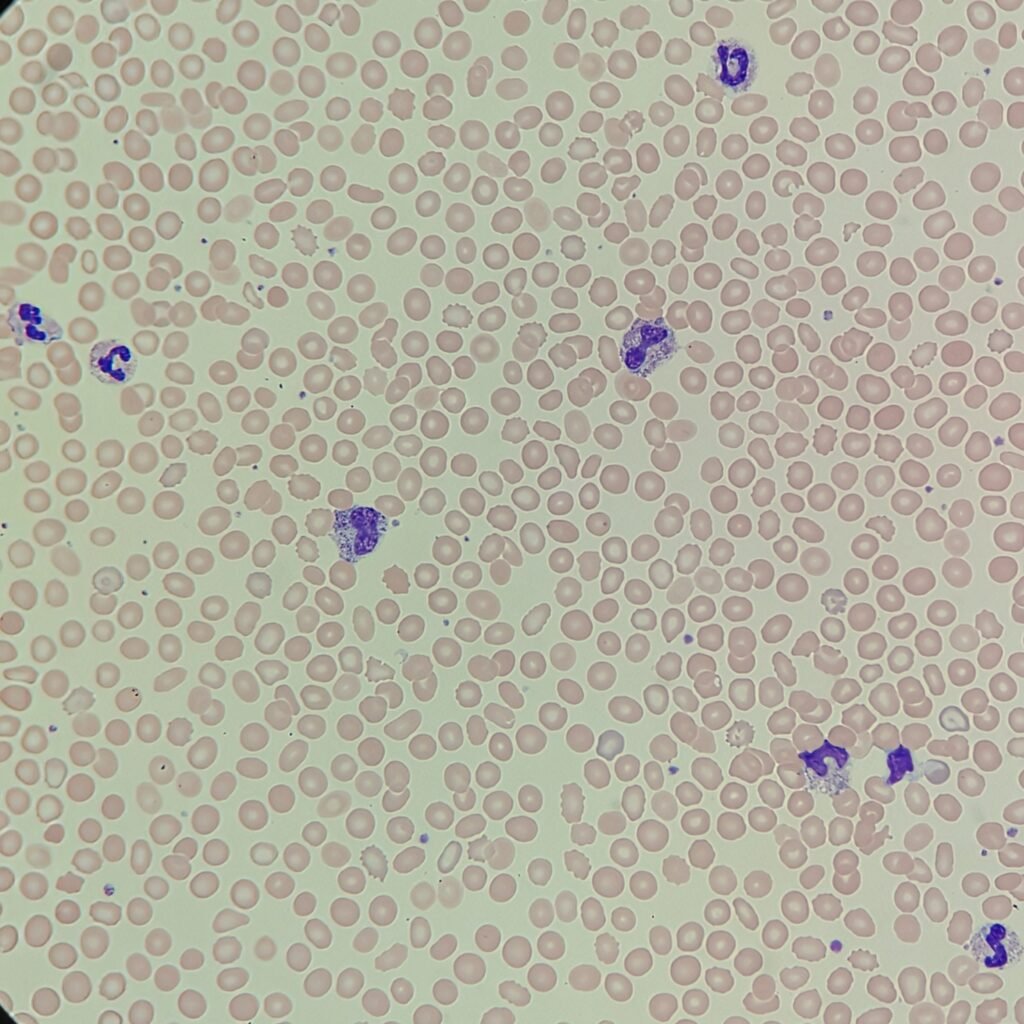
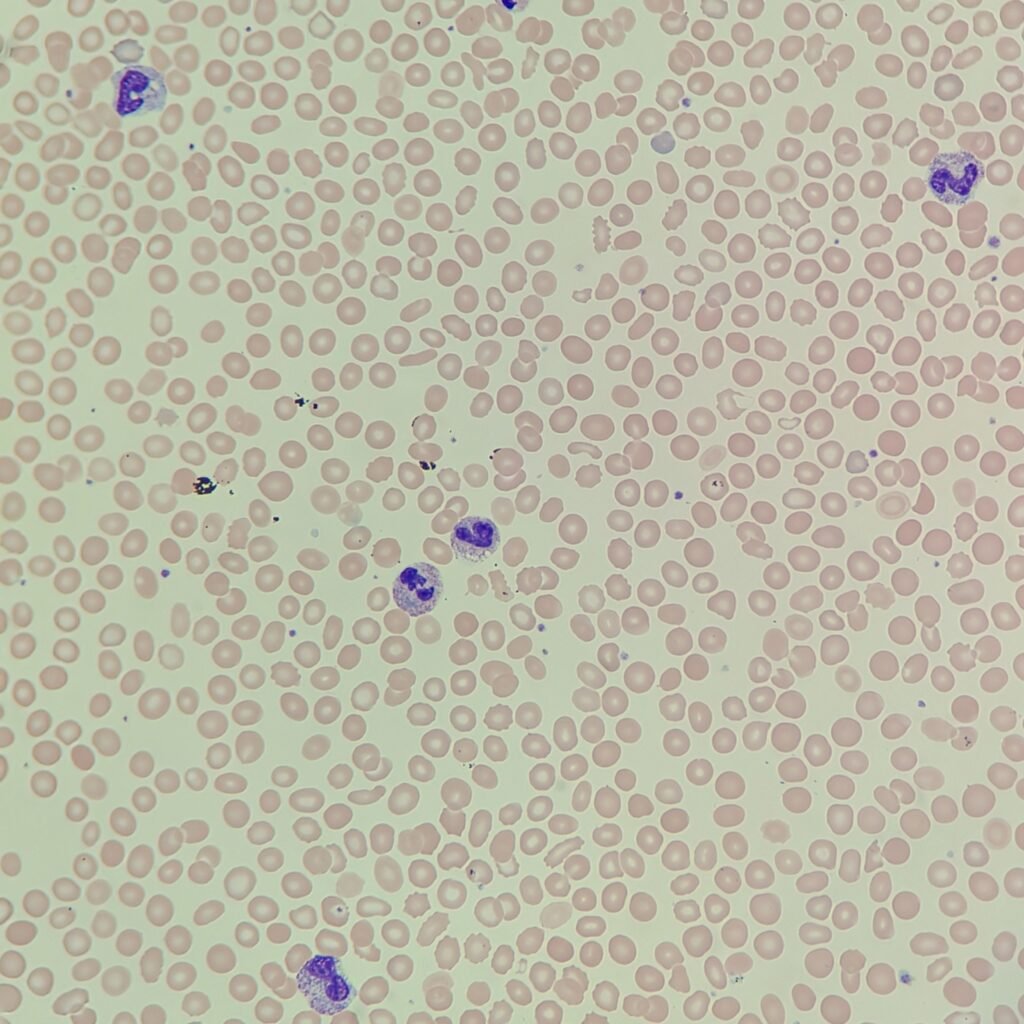

Analyzer Printout
If you would like to go in blind, skip straight to the images below. If you would like to know the analyzer results from the DXH 900, click to reveal.
Analyzer Complete Blood Count
| WBC | 13.2 ↑ |
| RBC | 3.76 ↓ |
| HGB | 10.3 ↓ |
| HCT | 34.2 |
| MCV | 90.9 |
| MCH | 27.5 |
| MCHC | 30.2 ↓ |
| RDW | 22.9 ↑ |
| PLT | 165 |
| MPV | 9.9 |
Analyzer Differential
| Neutrophils | 92.1% |
| Lymphocytes | 4.1% |
| Monocytes | 2.0% |
| Eosinophils | 0.2% |
| Basophils | 0.0% |

Based on the scatterplot, the instrument flagged for left shift and immature granulocytes.
Blood Smear

Answers
Click to Reveal

The manual differential shows a clear left shift with the majority of neutrophils being band. There are also a few metamyelocytes and myelocytes. There was also one nucleated red blood cell which is usually counted in addition to the 100 white blood cells. However, this differential counter is only set up for white cells at this time.
The neutrophils also have toxic granulation and vacuolization. It is difficult to see in the images, but dohle bodies were also noted. Along with the bands, this indicates an inflammatory response.
